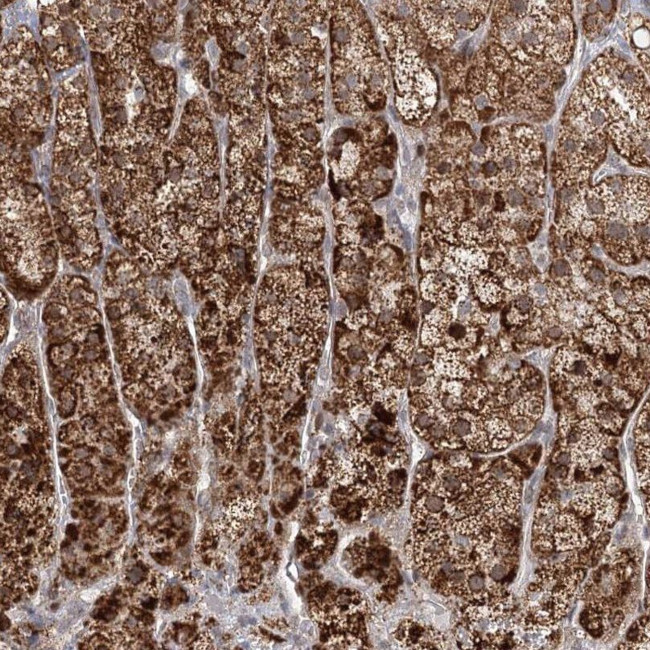
LACTB Antibody in Immunohistochemistry (IHC)

Search
Invitrogen
LACTB Polyclonal Antibody
{{$productOrderCtrl.translations['antibody.pdp.commerceCard.promotion.promotions']}}
{{$productOrderCtrl.translations['antibody.pdp.commerceCard.promotion.viewpromo']}}
{{$productOrderCtrl.translations['antibody.pdp.commerceCard.promotion.promocode']}}: {{promo.promoCode}} {{promo.promoTitle}} {{promo.promoDescription}}. {{$productOrderCtrl.translations['antibody.pdp.commerceCard.promotion.learnmore']}}
产品信息
PA5-57626
种属反应
宿主/亚型
分类
类型
抗原
偶联物
形式
浓度
规格
纯化类型
保存液
内含物
保存条件
运输条件
RRID
产品详细信息
Immunogen sequence: NSNENLLPGY LKPETMVMMW TPVPNTEMSW DKEGKYAMAW GVVEKKQTYG SCRKQRHYAS HTGGAVGASS VLLVLPEELD TETINNKVP
Highest antigen sequence identity to the following orthologs: Mouse - 97%, Rat - 94%.
靶标信息
This gene encodes a protein from the large 39S subunit of the mitochondrial ribosome (mitoribosome). The encoded protein has some sequence similarity to prokaryotic beta-lactamases but most of the residues that are responsible for the beta-lactamase activity are not conserved between the two proteins.
仅用于科研。不用于诊断过程。未经明确授权不得转售。
篇参考文献 (0)
生物信息学
蛋白别名: mitochondrial 39S ribosomal protein L56; Serine beta-lactamase-like protein LACTB, mitochondrial; serine beta-lactamase-like protein, mitochondrial; unnamed protein product
基因别名: G24; LACTB; MRPL56; UNQ843/PRO1781
UniProt ID: (Human) P83111
Entrez Gene ID: (Human) 114294